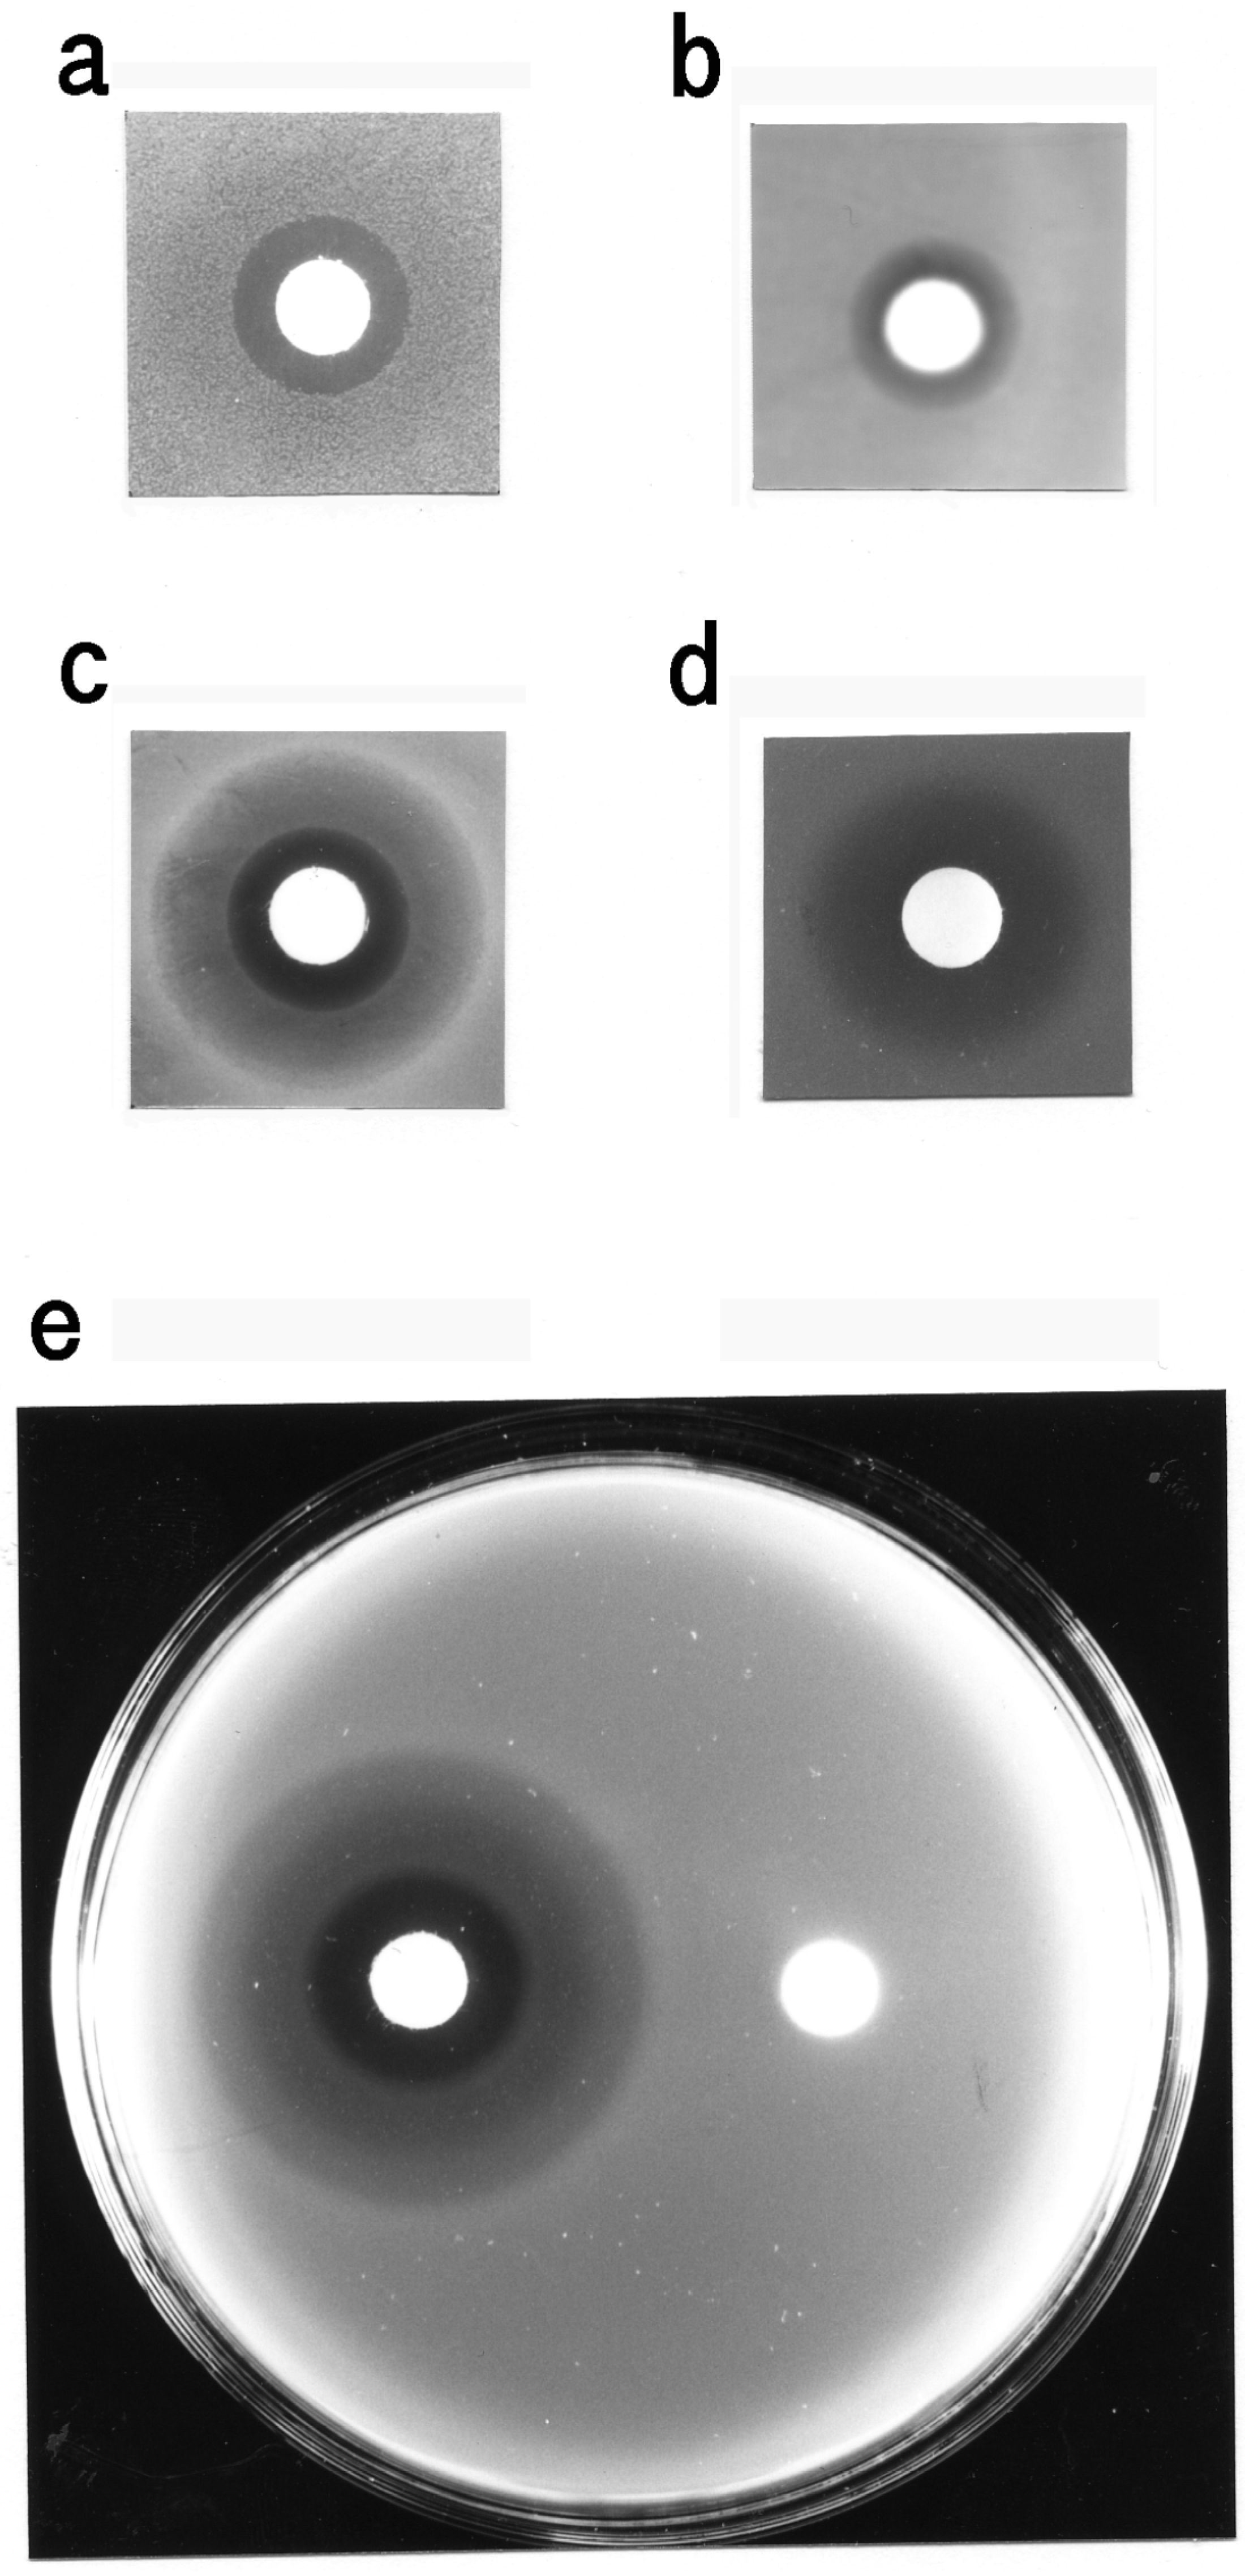
Membranes 04 00491 g006

Isolation and Characterization of Glycophorin from Carp Red Blood Cell Membranes
Abstract
:1. Introduction
2. Materials and Methods
2.1. Materials
2.2. Preparation of Red Blood Cell Membranes
2.3. Isolation of Glycophorin from the Red Blood Cell Membranes
2.4. SDS-Polyacrylamide Gel Electrophoresis (SDS-PAGE)
2.5. Miscellaneous Assays
2.6. Amino Acid Analysis
2.7. Preparation of the Carp Glycophorin Carbohydrate Fraction
2.8. High-Performance Liquid Chromatography (HPLC)
2.9. Desalting of Oligosaccharide Fractions
2.10. Preparation of Sialic Acid and Hexosamine from Carp Glycophorin
2.11. Thin Layer Chromatography (TLC)
2.12. Microbiological Assay
2.13. Electron Microscope
3. Results
3.1. Isolation and General Properties of Carp Glycophorin Molecule
| Component | Carp | Human *1 | Human *2 |
|---|---|---|---|
| Protein | 34.2 | 21.4 | 45.1 |
| Hexose | 55.2 | 26.4 | 12.2 |
| Sialic acid | 9.84 | 26.9 | 25.2 |
| Hexosamine | 0.78 | 25.2 | 16.2 |
| Amino acid | Carp | Human *1 | Human *2 |
|---|---|---|---|
| Aspartic acid | 7.25 | 8.90 | 6.7 |
| Threonine | 6.01 | 8.95 | 11.6 |
| Serine | 9.98 | 11.6 | 15.2 |
| Glutamic acid | 10.4 | 11.0 | 11.6 |
| Proline | 6.08 | 2.65 | 7.8 |
| Glycine | 6.01 | 8.49 | 4.8 |
| Alanine | 5.23 | 8.11 | 5.4 |
| Valine | 4.89 | 9.99 | 7.7 |
| Methionine | 1.32 | 0.14 | 1.3 |
| Isoleucine | 2.88 | 4.67 | 5.6 |
| Leucine | 5.26 | 8.60 | 5.3 |
| Tyrosine | 1.85 | 1.58 | 3.0 |
| Phenylalanine | 2.15 | 2.47 | 1.5 |
| Lysine | 14.7 | 5.12 | 4.0 |
| Histidine | 2.29 | 3.57 | 3.9 |
| Arginine | 8.72 | 3.97 | 4.8 |



3.2. Carbohydrate Moiety

3.3. Bacteriostatic Action of Carp Glycophorin

4. Discussion
Abbreviations
| NeuGc | N-glycolylneuraminic acid |
| Ac | acetyl |
| Fuc | fucose |
| Glc | glucose |
| Gal | galactose |
| GalNAc-ol | N-acetylgalactosaminitol |
Acknowledgements
Conflicts of Interest
References
- Chasis, J.A.; Mohandas, N. Red blood cell glycophorins. Blood 1992, 80, 1869–1879. [Google Scholar]
- Tanner, M.J.A. Molecular and cellular biology of the erythrocyte anion exchanger (AE1). Semin. Hemato. 1993, 30, 34–57. [Google Scholar]
- Weise, M.J.; Ingram, V.M. Proteins and glycoproteins of membranes from developing chick red cells. J. Biol. Chem. 1976, 251, 6667–6673. [Google Scholar]
- Watts, C.; Wheeler, K.P. Protein and lipid components of the pigeon erythrocyte membrane. Biochem. J. 1978, 173, 899–907. [Google Scholar]
- Dockham, P.A.; Vidaver, G.A. Comparison of human and pigeon erythrocyte membrane proteins by one- and two-dimensional gel electrophoresis. Comp. Biochem. Physiol. 1987, 87B, 171–177. [Google Scholar]
- Duk, M.; Krotkiewski, H.; Stasyk, T.V.; Lutsik-Kordovsky, M.; Syper, D.; Lisowska, E. Isolation and characterization of glycophorin from nucleated (Chicken) erythrocytes. Arch. Biochem. Biophys. 2000, 375, 111–118. [Google Scholar]
- Fukuda, M.; Dell, A.; Oates, J.E.; Fukuda, M.N. Structure of branched lactosaminoglycan, the carbohydrate moiety of band 3 isolated from adult human erythrocytes. J. Biol. Chem. 1984, 259, 8260–8273. [Google Scholar]
- Furthmayr, H. Structural comparison of glycophorins and immunochemical analysis of genetic variants. Nature 1978, 271, 519–524. [Google Scholar]
- Wybenga, L.E.; Epand, R.F.; Nir, S.; Chu, J.W.K.; Sharom, F.J.; Flanagan, T.D.; Epand, R.M. Glycophorin as a receptor for Sendai virus. Biochemistry 1996, 35, 9513–9518. [Google Scholar]
- Kanaseki, T.; Kawasaki, K.; Murata, M.; Ikeuchi, Y.; Ohnishi, S. Structural features of membrane fusion between influenza virus and liposome as revealed by quick-freezing electron microscopy. J. Cell Biol. 1997, 137, 1041–1056. [Google Scholar]
- Aoki, T.; Fukai, M.; Ueno, R. Glycoproteins in red cell membranes from carp and rainbow trout. Fisheries Sci. 1996, 62, 498–499. [Google Scholar]
- Jackson, R.C. The exterior surface of the chicken erythrocyte. J. Biol. Chem. 1975, 250, 617–622. [Google Scholar]
- Michel, F.; Rudloff, V. Isolation and characterization of the rainbow trout erythrocyte band-3 protein. Eur. J. Biochem. 1989, 181, 181–187. [Google Scholar]
- Hanahan, D.J.; Ekholm, J.E. The Preparation of Red Cell Ghosts (Membranes). Methods Enzymol. 1974, 31, 168–172. [Google Scholar]
- Marchesi, V.T.; Andrews, E.P. Glycoproteins: Isolation from cell membranes with lithium diiodosalicylate. Science 1971, 174, 1247–1248. [Google Scholar]
- Laemmli, U.K. Cleavage of structural proteins during the assembly of the head of bacteriophage T4. Nature 1970, 227, 680–685. [Google Scholar]
- Tuech, J.K.; Morrison, M. Human erythrocyte membrane sialoglycoproteins: A study of interconversion. Biochem. Biophys. Res. Commun. 1974, 59, 352–360. [Google Scholar]
- Fairbanks, G.; Steck, T.L.; Wallach, D.F.H. Electrophoretic analysis of the major polypeptides of the human erythrocyte membrane. Biochemistry 1971, 10, 2606–2617. [Google Scholar]
- Lowry, O.H.; Rosebrough, N.J.; Farr, A.L.; Randall, R.J. Protein measurement with the folin phenol reagent. J. Biol. Chem. 1951, 193, 265–275. [Google Scholar]
- Croft, D.N.; Lubran, M. The estimation of deoxyribonucleic acid in the presence of sialic acid: Application to analysis of human gastric washings. Biochem. J. 1965, 95, 612–620. [Google Scholar]
- Jourdian, G.W.; Dean, L.; Roseman, S. The sialic acids: XI. A periodate-resorcinol method for the quantitative estimation of free sialic acids and their glycosides. J. Biol. Chem. 1971, 245, 430–435. [Google Scholar]
- Dubois, M.; Gilles, K.A.; Hamilton, J.K.; Rebers, P.A.; Smith, F. Colorimetric method for determination of sugars and related substances. Anal. Chem. 1956, 28, 350–356. [Google Scholar]
- Moor, S.; Stein, W.H. A modified ninhydrin reagent for the photometric determination of amino acids and related compounds. J. Biol. Chem. 1954, 211, 907–913. [Google Scholar]
- Carlson, D.M. Structures and immunochemical properties of oligosaccharides isolated from pig submaxillary mucins. J. Biol. Chem. 1968, 243, 616–626. [Google Scholar]
- Packer, N.H.; Lawson, M.A.; Jardine, D.R.; Redmond, J.W. A general approach to desalting oligosaccharides released from glycoproteins. Glycoconj. J. 1998, 15, 737–747. [Google Scholar]
- Schauer, R. Characterization of Sialic Acids. Methods Enzymol. 1978, 50, 64–89. [Google Scholar]
- Boas, N.F. Method for the determination of hexosamines in tissues. J. Biol. Chem. 1953, 204, 553–563. [Google Scholar]
- Blix, G. The determination of hexosamines according to Elson and Morgan. Acta Chem. Scand. 1948, 2, 467–473. [Google Scholar]
- Bailey, R.W.; Bourne, E.J. Colour reactions given by sugars and diphenylamine-aniline splay reagents on paper chromatograms. J. Chromatogr. 1960, 4, 206–213. [Google Scholar]
- Azuma, J.; Janado, M.; Onodera, K. Heterogeneity of a human erythrocyte membrane glycoprotein. J. Biochem. 1973, 73, 1127–1130. [Google Scholar]
- Grefrath, S.P.; Reynolds, J.A. The molecular weight of the major glycoprotein from the human erythrocyte membrane. Proc. Natl. Acad. Sci. USA 1974, 71, 3913–3916. [Google Scholar]
- Blumenfeld, O.O.; Zvilichovsky, B. Isolation of Glycoproteins from Red Cell Membranes Using Pyridine. Methods Enzymol. 1972, 28, 245–252. [Google Scholar]
- Anstee, D.J.; Tanner, M.J.A. Structure and function of the red cell membrane sialoglycoproteins. Br. J. Haematol. 1986, 64, 211–215. [Google Scholar]
- Fukuda, K.; Tomita, M.; Hamada, A. Isolation and characterization of alkali-labile oligosaccharide units from horse glycophorin. J. Biochem. 1980, 87, 687–693. [Google Scholar]
- Fukuda, K.; Kawashima, I.; Tomita, M.; Hamada, A. Structural studies of the acidic oligosaccharide units from bovine glycophorin. Biochim. Biophys. Acta 1982, 717, 278–288. [Google Scholar]
- Kawashima, I.; Fukuda, K.; Tomita, M.; Hamada, A. Isolation and characterization of alkali-labile oligosaccharide units from porcine erythrocyte glycophorin. J. Biochem. 1982, 91, 865–872. [Google Scholar]
- Murayama, J.; Utsumi, H.; Hamada, A. Amino acid sequence of monkey erythrocyte glycophorin MK. its amino acid sequence has a striking homology with that of human glycophorin A. Biochim. Biophys. Acta 1989, 999, 273–280. [Google Scholar] [CrossRef]
- Sato, C.; Kitajima, K.; Tazawa, I.; Inoue, Y.; Inoue, S.; Troy, F.A., II. Structural diversity in the α2→8-linked polysialic acid chains in salmonid fish egg glycoproteins. J. Biol. Chem. 1993, 268, 23675–23684. [Google Scholar]
© 2014 by the authors; licensee MDPI, Basel, Switzerland. This article is an open access article distributed under the terms and conditions of the Creative Commons Attribution license (http://creativecommons.org/licenses/by/3.0/).
Share and Cite
Aoki, T.; Chimura, K.; Nakao, N.; Mizuno, Y. Isolation and Characterization of Glycophorin from Carp Red Blood Cell Membranes. Membranes 2014, 4, 491-508. https://doi.org/10.3390/membranes4030491
Aoki T, Chimura K, Nakao N, Mizuno Y. Isolation and Characterization of Glycophorin from Carp Red Blood Cell Membranes. Membranes. 2014; 4(3):491-508. https://doi.org/10.3390/membranes4030491
Chicago/Turabian StyleAoki, Takahiko, Kenji Chimura, Nobuhiro Nakao, and Yasuko Mizuno. 2014. "Isolation and Characterization of Glycophorin from Carp Red Blood Cell Membranes" Membranes 4, no. 3: 491-508. https://doi.org/10.3390/membranes4030491




